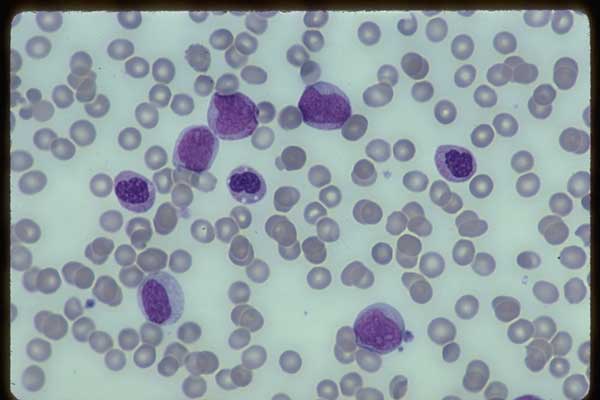

Зернистость гранулоцитов
Куда тратить монеты сокровищ в пабг
Лучшая аккумуляторная пила по дереву для сада
Авита квартиры посуточно
Вкусный соленый чеснок рецепт
Патрол 2025 года
Годи сайт
Заколка для челки мышь
Шуфутинский бутылка вина слушать
Save your tears weekend ariana
Окружающий мир подготовительная группа задания
Гидробур на мини экскаватор
Лайфхаки педагога
Мойка huter m420l отзывы
Зернистость гранулоцитов 106 фотографий